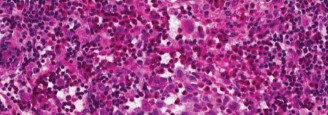
Image
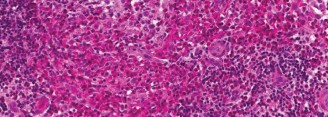
Image

Skeletal Langerhans Cell Histiocytosis: Orthopedic Diagnosis, Biomechanics & Management

Key Takeaway
Skeletal Langerhans Cell Histiocytosis (LCH) involves osteolytic bone lesions causing structural compromise. Orthopedic implications include pathological fracture risk, spinal instability, and neurological deficits. Management often requires diagnostic biopsy and intervention for fractures, instability, or disabling pain. A multidisciplinary approach is crucial for optimal outcomes.
Unraveling Langerhans Cell Histiocytosis in Orthopedic Oncology
Introduction & Epidemiology
Langerhans Cell Histiocytosis (LCH) represents a complex and heterogeneous disorder characterized by the clonal proliferation of CD1a+/CD207+ Langerhans cells, which are typically found in the epidermis and mucosa. While often regarded as an inflammatory myeloid neoplasm, its exact cellular origin and pathogenic mechanisms remain subjects of ongoing research and debate. The clinical spectrum ranges from solitary, self-limiting lesions to aggressive, multifocal, multisystem disease with significant morbidity and mortality.
Orthopedic involvement, specifically skeletal LCH, is a common presentation, accounting for 80-90% of all LCH cases. Any bone can be affected, but common sites include the skull, long bones (femur, humerus), vertebrae, and pelvis. LCH exhibits a bimodal age distribution, with a peak incidence in early childhood (1-4 years) and a smaller peak in adulthood (20-40 years). The incidence is estimated at 5-9 cases per million children per year, making it a rare disease. Men are slightly more affected than women. The primary concern in orthopedic oncology is the osteolytic nature of these lesions, which can compromise bone integrity, lead to pathological fractures, spinal instability, and neurological deficits. Accurate diagnosis and appropriate multidisciplinary management are paramount to optimize outcomes and minimize long-term sequelae.
Surgical Anatomy & Biomechanics
Skeletal involvement in LCH typically manifests as osteolytic lesions, which represent areas of bone destruction due to the infiltrating Langerhans cells, eosinophils, lymphocytes, plasma cells, and macrophages. The specific anatomical and biomechanical considerations are highly dependent on the lesion's location.
Common Sites and Their Implications:
- Skull: Cranial lesions, particularly in the temporal or parietal bones, can lead to localized pain, palpable masses, or rarely, neurological compromise if there is dural involvement or significant mass effect. Lesions can appear as "punched-out" lytic defects.
- Vertebrae: Vertebral involvement, known as vertebra plana, results from severe collapse of a vertebral body, often without posterior element involvement. This can lead to spinal deformity (kyphosis), back pain, and, critically, spinal instability or neurological deficits due to cord compression, although the latter is less common than expected given the degree of collapse. The thoracolumbar spine is most frequently affected.
- Long Bones (Femur, Humerus, Tibia): Diaphyseal or metaphyseal lesions are common. These lytic defects create stress risers, significantly increasing the risk of pathological fractures, particularly in weight-bearing bones. Lesions greater than 50% cortical circumference or exceeding 2.5 cm in diameter are generally considered at high risk for fracture.
- Pelvis: Pelvic lesions can be large and expansive, causing pain and, rarely, pelvic ring instability. Acetabular involvement can lead to hip pain and joint destruction.
- Ribs: Rib lesions are often asymptomatic but can present with localized pain or a palpable mass. The risk of pathological fracture is lower but still present.
Biomechanical Consequences:
The osteolytic process directly compromises the structural integrity of the affected bone.
*
Stress Risers:
Focal cortical defects concentrate mechanical stresses, significantly reducing the bone's tolerance to bending, torsional, and axial loads.
*
Reduced Load-Bearing Capacity:
In weight-bearing bones (femur, tibia, vertebrae), extensive lytic lesions diminish the bone's ability to withstand physiological forces, predisposing to collapse or fracture.
*
Spinal Instability:
Vertebral body destruction can lead to axial instability, segmental kyphosis, and potential encroachment on the neural elements. While vertebral plana in LCH often remodels with time, acute instability or progressive deformity necessitates intervention.
*
Growth Plate Involvement:
In pediatric patients, epiphyseal or metaphyseal lesions near growth plates can lead to growth disturbances, limb length discrepancies, or angular deformities.
Understanding these biomechanical implications is crucial for assessing fracture risk, planning surgical stabilization, and guiding post-operative rehabilitation.
Indications & Contraindications
The management of skeletal LCH requires a multidisciplinary approach, often involving orthopedic surgeons, oncologists, radiation oncologists, and endocrinologists. The decision for operative versus non-operative management is individualized based on the lesion's location, size, risk of pathological fracture, neurological compromise, and the presence of multifocal or multisystem disease.
Indications for Operative Intervention:
- Diagnostic Biopsy: Mandatory for definitive diagnosis, particularly to differentiate LCH from other bone tumors or inflammatory conditions. This is the most common orthopedic indication.
- Pathological Fracture: Acute fracture through an LCH lesion, requiring stabilization.
- Impending Pathological Fracture: Lesions with significant cortical destruction (>50% cortical involvement, lesions >2.5 cm, or specific Mirels score criteria) in weight-bearing bones or areas subjected to high mechanical stress.
- Spinal Instability/Neurological Deficit: Vertebral lesions causing progressive deformity, myelopathy, or radiculopathy.
- Painful, Disabling Lesions Refractory to Conservative Treatment: Persistent severe pain that significantly impacts quality of life, not responding to systemic therapy or local radiation.
- Recurrent Lesions: Local recurrence after previous non-operative or operative management that continues to be symptomatic or poses a risk.
- Aggressive Local Disease: Rapidly enlarging lesions or those causing significant local tissue destruction.
Contraindications for Operative Intervention:
- Asymptomatic, Solitary Lesions with Low Fracture Risk: Many LCH lesions, particularly in non-weight-bearing bones, can regress spontaneously or respond well to conservative management (observation, systemic chemotherapy, low-dose radiation).
- Extensive, Multifocal, Multisystem Disease: In cases of widespread disease, systemic chemotherapy is typically the primary treatment, and surgery is reserved for emergent complications (e.g., fracture, neurological compromise).
- Unfit for Surgery: Patients with severe comorbidities that preclude safe surgical intervention.
- Spontaneous Regression: Evidence of clear regression on serial imaging.
Table: Operative vs. Non-Operative Indications for Skeletal LCH
| Indication Category | Operative Management | Non-Operative Management |
|---|---|---|
| Diagnosis | Definitive biopsy (open or core needle) | N/A (biopsy is essential for diagnosis) |
| Fracture Risk | Pathological fracture; Impending fracture (Mirels score >8, >50% cortical lysis, large lesion in critical area) | Asymptomatic lesions with low fracture risk |
| Pain/Function | Severe, refractory pain; Functional impairment; Spinal instability or neurological deficit | Mild to moderate pain responsive to analgesia or systemic therapy |
| Disease Extent | Solitary or oligofocal disease amenable to local control | Multifocal/multisystem disease primarily managed systemically |
| Lesion Behavior | Progressive enlargement; Local recurrence after previous therapy | Stable lesion size; Spontaneous regression; Response to systemic therapy |
| Adjuvant Therapy | Local curettage often followed by adjuvant therapy (e.g., methylprednisolone injection, cryoablation) | Systemic chemotherapy (vinblastine, prednisone, cladribine); Low-dose radiation therapy |
Pre-Operative Planning & Patient Positioning
Thorough pre-operative planning is critical to ensure accurate diagnosis, achieve optimal local control, and prevent complications.
Diagnostic Workup:
-
Imaging:
- Plain Radiographs: Initial assessment, demonstrating osteolytic lesions with varying degrees of periosteal reaction and sclerosis.
- MRI: Essential for evaluating soft tissue extension, bone marrow involvement, spinal cord compression, and identifying additional lesions. T1-weighted sequences often show low signal intensity, while T2-weighted and STIR sequences reveal high signal intensity.
- CT Scan: Provides detailed assessment of cortical integrity, extent of bone destruction, fracture morphology, and bony anatomy, crucial for surgical planning, especially for spinal or complex joint lesions.
- PET/CT: Increasingly utilized for disease staging, identifying multifocal skeletal involvement, and assessing metabolic activity, which can guide biopsy and monitor treatment response.
-

Figure 1: Pre-operative axial CT scan demonstrating a lytic lesion involving the cortical bone of a long bone, highlighting the extent of bone destruction and potential for impending fracture.
- Laboratory Studies: Complete blood count, liver and kidney function tests, inflammatory markers.
- Systemic Staging: Bone scan (though often replaced by PET/CT), skeletal survey in younger patients, and thorough clinical examination to exclude multisystem disease.
Biopsy Planning:
- Type of Biopsy: Core needle biopsy is often sufficient and preferred to minimize morbidity. However, open biopsy may be required for difficult-to-access lesions, when core biopsy is non-diagnostic, or when a large sample is needed for immunohistochemistry and molecular analysis (e.g., BRAF V600E mutation testing).
- Pathology Consultation: Close collaboration with a musculoskeletal pathologist is essential. Frozen section analysis during open biopsy can guide intraoperative decisions regarding the extent of curettage or need for further sampling.
- Molecular Testing: Tissue should be sent for BRAF V600E mutation analysis, as this mutation is present in a significant proportion of LCH cases and informs targeted therapy options.
Surgical Planning for Resection/Stabilization:
- Approach Selection: Determined by the lesion's location, size, and need for exposure. Consideration of internervous planes, neurovascular structures, and reconstructive options.
- Reconstruction: Planning for bone defects (autograft, allograft, cement augmentation) and internal fixation (plates, screws, intramedullary nails) to restore structural integrity and stability.
- Contingency Planning: Preparation for potential complications such as hemorrhage or unexpected lesion characteristics.
Patient Positioning:
Patient positioning is dictated by the anatomical site of the LCH lesion.
*
Spinal Lesions:
Prone position for posterior approaches, often with a spinal frame (e.g., Jackson table) to facilitate lordosis and abdominal decompression, reducing epidural venous bleeding.
*
Long Bone Lesions (Femur/Tibia):
Supine position for anterior approaches (e.g., anterolateral thigh), lateral position for lateral approaches, or prone for posterior approaches. Care must be taken to pad pressure points.
*
Humeral Lesions:
Beach chair or supine with an arm board, depending on the approach (e.g., deltopectoral for proximal humerus, posterolateral for diaphyseal).
*
Pelvic Lesions:
Lateral, supine, or prone depending on the specific pelvic quadrant involved and the chosen approach (e.g., modified Stoppa for anterior ring, Kocher-Langenbeck for posterior column).
Image intensifier availability and accessibility must be ensured.
Detailed Surgical Approach / Technique
Surgical intervention for skeletal LCH typically involves biopsy for diagnosis, followed by local control measures such as curettage, often combined with adjuvant therapies, and stabilization for impending or actual fractures. The specific technique varies widely based on the lesion's location.
1. Biopsy and Diagnostic Confirmation:
- Incision: A carefully planned incision, often longitudinal, that can be incorporated into a definitive reconstructive approach if required. Avoid large, transverse incisions, especially over long bones.
- Soft Tissue Dissection: Dissection proceeds through appropriate internervous planes, protecting neurovascular structures. Meticulous hemostasis is crucial.
- Bone Exposure: The involved bone is exposed. A cortical window is created using an osteotome or burr, ensuring sufficient size for biopsy sampling.
-
Tissue Sampling:
Multiple samples are obtained from the periphery and center of the lesion. These should be sent for routine histopathology, immunohistochemistry (CD1a, CD207, S100), and molecular studies (BRAF V600E). Frozen section analysis can confirm the presence of lesional tissue but is not diagnostic for LCH.
-

Figure 2: Intraoperative view of a bone lesion after creating a cortical window, showing tissue being harvested for biopsy. Note the friable, often yellowish-brown appearance characteristic of LCH lesions.
-
2. Local Control: Curettage and Adjuvant Therapy:
- Thorough Curettage: Once diagnostic samples are secured and LCH is confirmed (or highly suspected), meticulous curettage of the lesion is performed using curettes of various sizes. The goal is to remove all visible lesional tissue, including the endosteal surface, to achieve maximal local control. The margins are often soft and friable.
-
Adjuvant Local Therapy:
- Intralesional Corticosteroids: Methylprednisolone acetate injection (e.g., 80-120 mg) into the curetted cavity is a well-established adjuvant, thought to reduce local recurrence and promote bone healing.
- Cryoablation: In some centers, cryoablation can be used after curettage to destroy residual cells in the cavity.
- Phenol: Application of phenol can also be used, but with caution due to its systemic toxicity and local tissue damage.
- High-speed Burring: Debridement of the cavity walls with a high-speed burr can further remove microscopic disease and promote bleeding for graft integration.
3. Reconstruction and Stabilization:
The defect created by curettage may require reconstruction, especially in weight-bearing bones or large lesions, to prevent pathological fracture.
*
Bone Grafting:
*
Autograft:
Cancellous autograft (e.g., from iliac crest) is the gold standard, providing osteoinductive and osteoconductive properties, promoting bone healing.
*
Allograft:
Demineralized bone matrix (DBM) or cancellous allograft can be used, particularly for larger defects, though without the osteoinductive capacity of autograft.
*
Cement Augmentation:
Polymethyl methacrylate (PMMA) cement can be used, especially in adult patients or for lesions in areas requiring immediate load-bearing capacity (e.g., vertebral body, periacetabular). Cement provides immediate structural support but lacks osteoinductive properties.
*
Internal Fixation:
*
Plates and Screws:
Used for diaphyseal or metaphyseal lesions in long bones, particularly when a pathological fracture is present or impending.
*
Intramedullary Nailing:
Preferred for diaphyseal lesions of long bones due to its load-sharing capabilities and minimally invasive nature.
*
Spinal Stabilization:
For vertebral lesions with instability or neurological deficit, posterior instrumentation (pedicle screws and rods) may be required, often combined with anterior column reconstruction (e.g., cage, vertebrectomy).
*
Figure 3: Post-curettage image of a long bone defect filled with bone graft and augmented with cement, prior to definitive internal fixation for stabilization.
*
Figure 4: Post-operative radiograph demonstrating stable internal fixation of a pathological femoral fracture through an LCH lesion, with adequate reduction and hardware placement.
4. Wound Closure:
- Thorough irrigation of the surgical site.
- Hemostasis is re-checked.
- Layered closure of soft tissues.
- Skin closure with appropriate technique. Drain placement may be considered depending on the extent of dissection.
Complications & Management
Despite meticulous surgical technique and comprehensive management, complications can arise in the treatment of skeletal LCH. These can be related to the disease itself, the surgical intervention, or adjuvant therapies.
Common Complications:
| Complication | Incidence | Salvage Strategies / Management |
|---|---|---|
| Local Recurrence | 10-20% (higher for spine/skull) | Re-curettage, repeat intralesional steroid injection, systemic chemotherapy (e.g., vinblastine/prednisone, cladribine, BRAF inhibitors for BRAF-mutated cases), low-dose radiation therapy, observation if asymptomatic and small. |
| Pathological Fracture | Variable, depending on initial risk | Open reduction internal fixation (ORIF) with robust implants, often requiring bone grafting or cement augmentation. Revision surgery if initial fixation fails. Systemic therapy to address underlying disease. |
| Infection (Surgical Site) | Low, but serious (approx. 1-5%) | Aggressive debridement, intravenous antibiotics (culture-directed), hardware removal if necessary (after bone healing or definitive reconstruction), soft tissue coverage procedures. |
| Spinal Instability/Deformity | Less common with isolated LCH, higher if severe vertebral collapse | Surgical stabilization (posterior instrumentation, anterior column reconstruction), bracing in some cases. Physical therapy. Monitoring for progression. |
| Neurological Deficit | Rare, but possible with spinal/cranial lesions | Urgent surgical decompression, spinal stabilization, steroid administration. Multidisciplinary neurosurgical/orthopedic spine input. |
| Hardware Failure | Variable, depending on defect size and fixation method | Revision surgery with stronger fixation, larger plates, or conversion to intramedullary device. Consider cement augmentation. Address underlying bone quality issues. |
| Growth Disturbance (Pediatric) | Rare, with epiphyseal/physeal involvement | Monitoring for limb length discrepancy or angular deformity. Epiphysiodesis on the contralateral side for severe discrepancy, osteotomy for angular deformity. Growth plate-sparing techniques during initial surgery where possible. |
| Avascular Necrosis | Rare, reported in femoral head/other joints | Conservative management (protected weight-bearing) for early stages. Surgical intervention (core decompression, osteotomy, arthroplasty) for advanced stages, especially hip. |
| Systemic Disease Progression | Variable, depending on initial staging | Intensified systemic chemotherapy regimens, targeted therapy (e.g., BRAF inhibitors for BRAF V600E-mutated disease), enrollment in clinical trials. Close monitoring by oncology. |
| Delayed Union/Non-Union | Less common, LCH lesions typically heal well with graft | Revision with more aggressive bone grafting, biological augmentation (e.g., bone morphogenetic proteins), pulsed electromagnetic fields, or re-fixation with more stable constructs. |
Management Principles:
- Early Recognition: Prompt identification and diagnosis are key to appropriate management.
- Multidisciplinary Team: Close collaboration among orthopedic surgeons, pediatric/adult oncologists, radiation oncologists, radiologists, and pathologists is essential for optimal patient care.
- Individualized Treatment: Tailoring treatment plans to the specific patient, lesion characteristics, and disease extent is critical.
- Long-term Surveillance: Regular clinical and radiological follow-up is necessary to monitor for recurrence, healing, and potential long-term complications, especially in children where growth modulation is a concern.
Post-Operative Rehabilitation Protocols
Post-operative rehabilitation following surgical management of skeletal LCH is critical for maximizing functional recovery, promoting bone healing, and minimizing complications. The specific protocol is highly individualized, depending on the anatomical site of the lesion, the extent of bone involvement, the type of surgical reconstruction and stabilization performed, and the patient's age and comorbidities.
General Principles:
- Protection of Surgical Site: Safeguard against undue stress on the treated bone or reconstructed area to allow for healing and graft incorporation.
- Gradual Mobilization: Progressive increase in range of motion and weight-bearing activities.
- Pain Management: Effective pain control to facilitate participation in rehabilitation.
- Monitoring for Complications: Vigilance for signs of infection, recurrence, or hardware failure.
Phase 1: Immediate Post-Operative (Days 0-14)
- Pain Management: Oral or intravenous analgesics, often including NSAIDs (if not contraindicated by systemic therapy) and opioids.
-
Immobilization/Bracing:
- Spine: Orthosis (e.g., TLSO) if extensive spinal stabilization was performed or if concerns for residual instability exist. Early mobilization out of bed with assistance.
- Long Bones: Protected weight-bearing or non-weight-bearing (NWB) with crutches, walker, or wheelchair, depending on the bone and stability of fixation. Often, a brace or cast is not required if internal fixation is rigid.
- Upper Extremity: Sling for comfort and protection (e.g., humerus).
-
Early Range of Motion (ROM):
- Non-operated Joints: Maintain full ROM for adjacent joints.
- Operated Joint (if applicable): Gentle, passive or active-assisted ROM as tolerated, especially for periarticular lesions, to prevent stiffness. Avoid forceful movements.
- Soft Tissue Care: Wound checks, dressing changes, monitor for signs of infection.
Phase 2: Early Recovery & Bone Healing (Weeks 2-12)
-
Weight-Bearing Progression (Lower Extremity):
- Gradual progression from NWB to toe-touch weight-bearing (TTWB), partial weight-bearing (PWB), and then full weight-bearing (FWB) as determined by radiographic evidence of healing and stability of fixation. This often involves serial radiographs at 4-6 week intervals.
- Criteria for progression may include absence of pain, callus formation, and no evidence of hardware loosening.
-
Strength Training:
- Isometrics for muscles surrounding the surgical site (e.g., quadriceps sets, gluteal sets).
- Gentle, progressive resistive exercises for uninjured limbs and eventually for the involved limb, once stability is confirmed.
- Range of Motion: Continue active and passive ROM exercises to restore full joint mobility.
- Functional Mobility: Gait training with assistive devices, balance exercises.
Phase 3: Advanced Rehabilitation & Return to Activity (Weeks 12-Beyond)
- Full Weight-Bearing: Typically achieved once robust bone healing is evident radiographically.
- Advanced Strengthening: Progressive resistance training, proprioceptive exercises, and functional movement patterns.
- Sport-Specific Training: For younger patients or athletes, gradual reintroduction to sport-specific drills, agility training, and plyometrics.
- Endurance Training: Cardiovascular conditioning.
- Monitoring: Continued clinical and radiological surveillance to detect recurrence, particularly for the first 1-2 years post-surgery. Follow-up frequency is typically quarterly for the first year, then every 6-12 months.
Special Considerations:
- Spinal Lesions: Emphasize core strengthening and postural education to maintain spinal stability and prevent future deformity.
- Pediatric Patients: Special attention to potential growth plate disturbance. Rehabilitation needs to be age-appropriate and engage the child.
- Multisystem Disease: Rehabilitation may be impacted by systemic chemotherapy side effects. Close coordination with the oncology team is paramount.
- Psychosocial Support: LCH can be a challenging diagnosis, particularly for families. Providing psychosocial support and education is an integral part of holistic care.
Summary of Key Literature / Guidelines
The understanding and management of Langerhans Cell Histiocytosis have evolved significantly over the past decades, driven by collaborative research and molecular insights. Several key organizations and publications provide foundational guidance for orthopedic oncologists.
Diagnostic and Staging Guidelines:
- Histiocyte Society Guidelines: The International Histiocyte Society (IHS) is the leading international body for LCH research and clinical guidelines. Their consensus documents provide comprehensive recommendations for diagnosis, staging, risk stratification, and treatment algorithms for LCH. These guidelines emphasize the critical role of immunohistochemistry (CD1a, CD207, S100) for definitive diagnosis and the need for thorough staging to identify single-system (SS-LCH) versus multi-system (MS-LCH) disease, and to classify MS-LCH based on "risk organs" (liver, spleen, hematopoietic system).
- Imaging Modalities: Contemporary guidelines advocate for a detailed skeletal survey or whole-body MRI, and increasingly PET/CT, for comprehensive assessment of skeletal involvement and to exclude multifocal disease. CT is crucial for assessing cortical integrity and fracture risk in specific lesions.
Treatment Paradigms:
- Systemic Therapy: For MS-LCH and recurrent SS-LCH, systemic chemotherapy, typically vinblastine and prednisone, remains the backbone of treatment. Cladribine (2-CdA) is often used for refractory or high-risk disease.
- Targeted Therapy (BRAF V600E Mutation): The discovery of the BRAF V600E mutation in approximately 50% of LCH cases has revolutionized treatment for a subset of patients. Inhibitors like vemurafenib or dabrafenib have shown remarkable efficacy, particularly in refractory or high-risk MS-LCH. Molecular testing for BRAF V600E is now a standard component of initial diagnostic workup, guiding treatment decisions.
-
Local Treatment:
- Curettage and Intralesional Steroids: Numerous studies and clinical experience support the efficacy of local curettage combined with intralesional corticosteroid injection for solitary or limited skeletal lesions. This approach offers excellent local control and promotes bone healing with minimal systemic side effects. Studies by Ye et al. (2010) and Suh et al. (2016) underscore the effectiveness and low recurrence rates with this technique in pediatric and adult populations.
- Low-Dose Radiation Therapy: Indicated for painful, inaccessible, or recurrent lesions that do not respond to other local therapies, or for sites at high risk of fracture. Doses typically range from 5-10 Gy in fractionated doses. Its use is more cautious in pediatric patients due to concerns about growth plate damage and secondary malignancy.
- Surgical Stabilization: As discussed, surgical fixation for pathological or impending fractures is a well-established practice, aiming to restore stability and function. The choice of fixation depends on the location and extent of the lesion, often combined with local curettage and reconstruction.
Prognosis and Surveillance:
- Prognosis: The prognosis for SS-LCH with skeletal involvement is generally excellent, especially with appropriate local control. MS-LCH, particularly with risk organ involvement, carries a more guarded prognosis, although outcomes have improved with modern systemic therapies.
- Surveillance: Long-term follow-up is critical due to the potential for disease recurrence (local or systemic) and the development of long-term complications such as orthopedic sequelae (e.g., spinal deformity, growth disturbance, avascular necrosis), diabetes insipidus, or neurological deficits. Regular clinical examinations and imaging (e.g., skeletal surveys, MRI) are recommended.
In summary, the management of skeletal LCH requires a sophisticated, evidence-based, and multidisciplinary approach. Orthopedic surgeons play a crucial role in diagnosis, local control, and stabilization of skeletal lesions, working in close conjunction with medical oncologists to integrate local interventions with systemic therapies for optimal patient outcomes. The evolving understanding of LCH biology and the advent of targeted therapies continue to refine treatment algorithms, offering improved prospects for patients affected by this intriguing disease.
You Might Also Like

